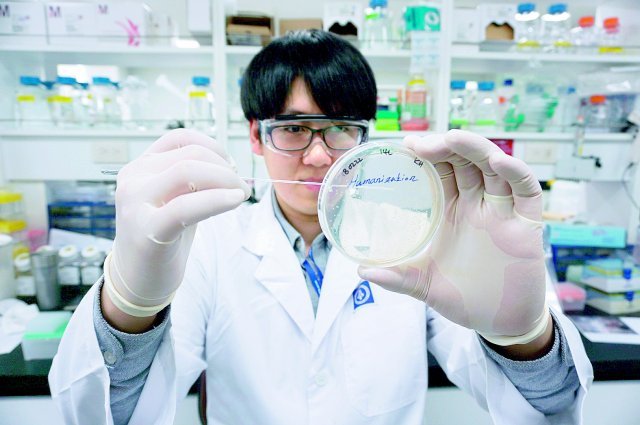

공유하기
5년 연속 임상 건수 최다 1위, ‘미충족 수요 시장’ 공략 시동
- 동아일보
글자크기 설정
종근당
종근당이 연구개발비 투자와 연구개발 파이프라인을 대폭 확대하며 신약 개발에 속도를 높이고 있다. 2021년 매출액 대비 12.2%인 1628억 원을 투자해 연구개발 파이프라인을 2년 새 56개에서 87개로 31개 확대한 데 이어 지난해 국내 임상 승인 21건으로 5년 연속 임상 건수 최다 1위를 기록하며 세상에 없던 신약과 미충족 수요 의약품을 타깃으로 연구개발에 집중하고 있다.
최근에는 유전자 치료제, 세포 치료제와 같은 첨단 바이오 의약품과 ADC 항암제 등으로 신약 개발 범위를 확대하고 있다. 지난해 5월 세포유전자 치료제 위탁 개발 생산(CDMO) 및 차세대 줄기세포 치료제 개발 기업 이엔셀과 전략적 투자 및 세포유전자 치료제 공동 연구를 위한 양해각서(MOU)를 체결한 바 있다. 최근에는 네덜란드의 시나픽스와 항체-약물 접합체 기술 도입 계약을 체결하고 항체-약물 접합체 플랫폼 기술 3종 GlycoConnect™, HydraSpace™, toxSYN™의 사용 권리를 확보해 ADC 항암제 개발에도 나서고 있다. 연구-임상시험과 관련해 산학연 협력과 교류를 강화하고 국내·외 기업들과 오픈 이노베이션을 통한 공동 개발도 진행하겠다는 전략이다.
바이오 의약품 개발로 미래 먹거리 확보
종근당은 지난해 10월 식품의약품안전처로부터 황반변성치료제 바이오시밀러 ‘루센비에스(CKD-701)’의 품목 허가를 받았다. 루센비에스는 라니비주맙을 주성분으로 하는 고순도의 루센티스 바이오시밀러로 종근당의 순수 독자 기술인 항체절편 원료 제조 기술로 양산돼 황반변성 및 당뇨병성 황반부종 등에 사용되는 안과 질환 치료제다. 
글로벌 시장에서 주목하는 혁신 신약
종근당은 지난해 5월 미국 마이애미에서 열린 국제 말초신경학회에서 샤르코-마리-투스(CMT) 신약 CKD-510의 유럽 임상 1상 및 비임상 연구 결과를 발표했다. CKD-510은 히스톤탈아세틸화효소6(HDAC6)를 저해하는 비하이드록삼산(Non-hydroxamic acid) 플랫폼 기술이 적용된 차세대 신약 후보 물질이다. 발표에 따르면 CKD-510은 건강한 성인 87명을 대상으로 진행된 임상 1상에서 약물의 우수한 안전성과 내약성이 입증돼 유럽 임상 2상을 준비하고 있다. CKD-510은 2020년 3월 미국 식품의약국(FDA)으로부터 샤르코-마리-투스 치료제로 희귀의약품 지정을 받은 바 있다. 비이온 채널 차단제로서 심장의 리듬 조절과 심박수 조절 치료뿐만 아니라 질환의 근본 원인도 개선하는 새로운 개념의 치료제로 기대를 받고 있다. 이번 전임상 결과를 바탕으로 심방세동뿐만 아니라 다양한 심장질환에서 치료제로서의 가능성을 확인하기 위해 연구를 진행해 나갈 계획이다.
© dongA.com All rights reserved. 무단 전재, 재배포 및 AI학습 이용 금지
트렌드뉴스
-
1
‘월급 50만원, 아파트는 4억’ 베트남…청년들 “그냥 평생 월세 살란다”[딥다이브]
-
2
한동훈 “2030년 정권 되찾겠다…2028년 총선 ‘보수 다수당’ 목표”
-
3
내년 환갑이지만…“근육운동 덕분에 은퇴 뒤 설계까지 끝내”[양종구의 100세 시대 건강법]
-
4
‘멸공라떼’ 내놓은 대전 카페, 태극기 잘못 그려…건곤감리 틀려 역풍
-
5
‘집회가요, 지도부, 인쇄물’ 없는 이런 시위는 처음 본다[청계천 옆 사진관]
-
6
“이화영 유죄, 李정권 ‘무고의 굿판’ 끝…민주당 사과해야” 野 맹공
-
7
“내 신청곡 왜 취소해” 소주병으로 머리 내려친 70대 산악회원
-
8
李 조작기소 특검 발단 “연어 술파티”…법원 판단은 “거짓말”
-
9
“1000만원 줄 테니 나가달라”…집주인 제안, 받아도 될까 [집과법]
-
10
반도체→부동산 ‘富의 이동’ 원천차단?…‘보유-양도세’ 꺼낸 김용범
-
1
[단독]노태악, 선관위서 수당 4년간 1.8억 받아…3배 ‘셀프 증액’도
-
2
위기때면 단식-입원, ‘소나기’ 피하는 장동혁
-
3
李 조작기소 특검 발단 “연어 술파티”…법원 판단은 “거짓말”
-
4
李 “선관위 원포인트 개헌, 필요땐 대통령 발의”
-
5
한동훈 “2030년 정권 되찾겠다…2028년 총선 ‘보수 다수당’ 목표”
-
6
“투표지 축소 인쇄 보고 못받았다”던 노태악, 뒤늦게 말바꿔
-
7
李 “우리 돈으로 우리 방위 책임질건데, 전작권 왜 美가 갖나”
-
8
李 “우리 돈으로 방위 책임, 전작권 왜 美가 갖나”
-
9
‘멸공라떼’ 내놓은 대전 카페, 태극기 잘못 그려…건곤감리 틀려 역풍
-
10
李, 민주당 직격 “원수 싸우듯 하지말라…패싸움하면 되겠나”
트렌드뉴스
-
1
‘월급 50만원, 아파트는 4억’ 베트남…청년들 “그냥 평생 월세 살란다”[딥다이브]
-
2
한동훈 “2030년 정권 되찾겠다…2028년 총선 ‘보수 다수당’ 목표”
-
3
내년 환갑이지만…“근육운동 덕분에 은퇴 뒤 설계까지 끝내”[양종구의 100세 시대 건강법]
-
4
‘멸공라떼’ 내놓은 대전 카페, 태극기 잘못 그려…건곤감리 틀려 역풍
-
5
‘집회가요, 지도부, 인쇄물’ 없는 이런 시위는 처음 본다[청계천 옆 사진관]
-
6
“이화영 유죄, 李정권 ‘무고의 굿판’ 끝…민주당 사과해야” 野 맹공
-
7
“내 신청곡 왜 취소해” 소주병으로 머리 내려친 70대 산악회원
-
8
李 조작기소 특검 발단 “연어 술파티”…법원 판단은 “거짓말”
-
9
“1000만원 줄 테니 나가달라”…집주인 제안, 받아도 될까 [집과법]
-
10
반도체→부동산 ‘富의 이동’ 원천차단?…‘보유-양도세’ 꺼낸 김용범
-
1
[단독]노태악, 선관위서 수당 4년간 1.8억 받아…3배 ‘셀프 증액’도
-
2
위기때면 단식-입원, ‘소나기’ 피하는 장동혁
-
3
李 조작기소 특검 발단 “연어 술파티”…법원 판단은 “거짓말”
-
4
李 “선관위 원포인트 개헌, 필요땐 대통령 발의”
-
5
한동훈 “2030년 정권 되찾겠다…2028년 총선 ‘보수 다수당’ 목표”
-
6
“투표지 축소 인쇄 보고 못받았다”던 노태악, 뒤늦게 말바꿔
-
7
李 “우리 돈으로 우리 방위 책임질건데, 전작권 왜 美가 갖나”
-
8
李 “우리 돈으로 방위 책임, 전작권 왜 美가 갖나”
-
9
‘멸공라떼’ 내놓은 대전 카페, 태극기 잘못 그려…건곤감리 틀려 역풍
-
10
李, 민주당 직격 “원수 싸우듯 하지말라…패싸움하면 되겠나”
-
- 좋아요
- 0개
-
- 슬퍼요
- 0개
-
- 화나요
- 0개



댓글 0